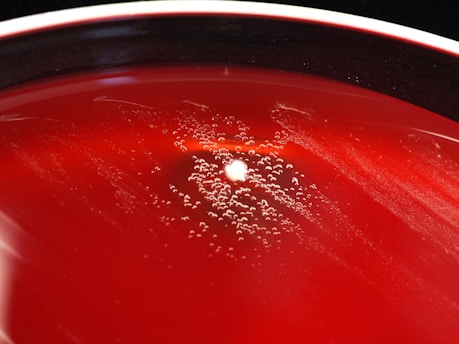
Close-up of glowing microbial cultures fermenting organic waste in a bioreactor.

Our Proprietary Waste-to-Wealth Platform
PHAsys BioTech has engineered a proprietary and commercially scalable waste-to-wealth platform. Our process efficiently converts low-value organic waste streams, like food waste and waste lipids, into high-value polyhydroxyalkanoates (PHAs), creating a cost-effective and truly circular alternative to petroleum-based plastics
Microbial Magic
Specialized microbes convert organic waste into valuable PHA polymers efficiently

Green Process
Eco-friendly extraction yields pure, high-grade biopolymer resin ready for use


PHA Polymers
Biodegradable plastics from organic waste


Microbial Fermentation
Our proprietary microbes convert organic feedstock into valuable biopolymers through a carefully controlled fermentation process, maximizing yield and sustainability


Green Extraction
We use environmentally friendly methods to extract pure, high-grade PHA resin, ensuring minimal waste and energy use for scalable production
Our Story
From university labs to real-world impact, we transform waste into eco-friendly materials






